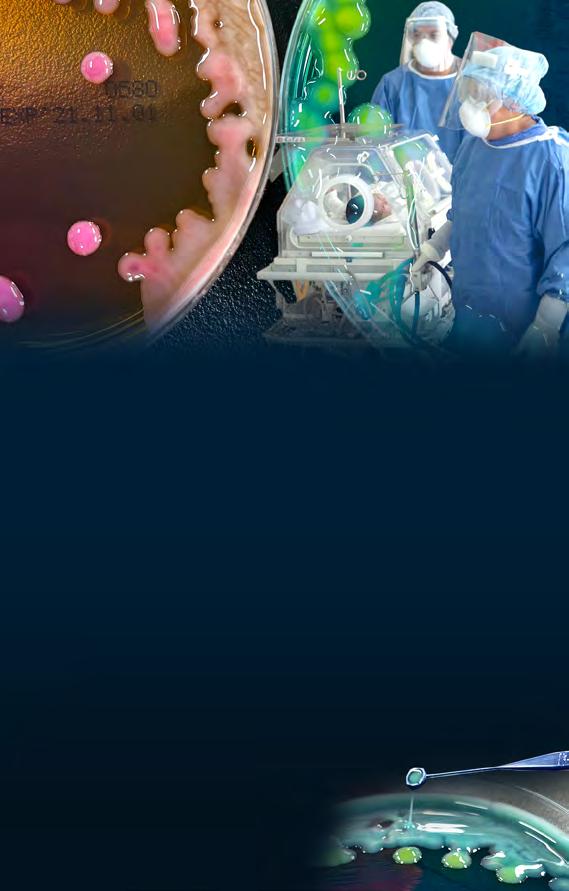

TALENTO Iluminan jóvenes
ciudad zapatera
León Light Fest busca ser semillero de desarrolladores visuales >13


![]()
TALENTO Iluminan jóvenes
ciudad zapatera
León Light Fest busca ser semillero de desarrolladores visuales >13


LOGRÓ DISMINUIR 16.94% LOS HOMICIDIOS DOLOSOS EN NOVIEMBRE Y
54.79% LOS ROBOS AL TRANSPORTE FEDERAL, GRACIAS A LA COORDINACIÓN
ENTRE LAS FSPE, SEDENA, GUARDIA NACIONAL Y POLICÍAS MUNICIPALES >5

INFRAESTRUCTURA
Estado tendrá tres hospitales en el actual sexenio
Guanajuato será el único que construya tres complejos del IMSS >2

ISSEG
Reconoce Libia a jubilados y pensionados
Recibieron el pago al complemento del aguinaldo y bono estatal >3


SHEINBAUM
Buscará que deporten migrantes a sus países
Pide que los no paisanos no pasen por México, si concretan deportaciones >8



Por ahora sólo se conocen las de la Capital e Irapuato
Durante los próximos seis años, Guanajuato será el único Estado en México que cuente con la construcción de tres hospitales generales del IMSS, informó el delegado estatal, Marco Antonio Hernández.
Sin dar detalles de cuál será el Municipio que albergue un tercer nosocomio, el funcionario sostuvo que se prevé otra clínica para el Estado; esto se dio a conocer durante la entrega de escrituras del nuevo hospital en Irapuato.
Por otro lado, se informó que el edificio que se construye en Guanajuato Capital lleva un avance superior al 30%, contará con 72 camas y tendrá una inversión de mil 900 millones de pesos.
“En los próximos seis años Guanajuato va a tener tres hospitales, no va haber ningún otro Estado de la República que tenga tres hospitales en el mismo sexenio, Guanajuato Capital, Irapuato y el otro todavía no sabemos”, explicó Hernández Carrillo.

ANIVERSARIO CUMPLE 31 AÑOS EL METROPOLITANO ESTE PARQUE, ÁREA NATURAL PROTEGIDA ES HOGAR DE MÁS DE 204 ESPECIES, ENTRE AVES MIGRATORIAS Y RESIDENTES, ADEMÁS DE SER PUNTO DE REUNIÓN DE MILES DE FAMILIAS Y ESCENARIO PARA EVENTOS COMO EL FIG. AL AÑO RECIBE UN MILLÓN 500 MIL VISITANTES
Alumnos, docentes y asesores destacados a nivel nacional e internacional fueron galardonados con el reconocimiento Talentos Cecyteg 2024, en su primera edición.
Este premio se entregó a 100 docentes y presidentes de academia de los diferentes planteles, así como a 160 alumnas y alumnos, y 30 asesores destacados en las áreas de Cívica; Deporte; Robótica Educativa; Competencias Laborales; Ciencia, Tecnología e Innovación; Emprendimiento Académico y Sustentabilidad.
Antonio Villegas Romero, alumno del plantel Pueblo Nuevo e integrante del proyecto CAS 2.0, detalló su proceso de aprendizaje y destacó los logros obtenidos en Expo Ciencias 2023
Guanajuato, Expo Ciencias Nacional Sonora, Infomatrix Nacional México, y su mayor logro, el American Association Convention, organizado por Henry Ford, donde su equipo ganó un

Logro. El premio Talentos Cecyteg 2024 fue para 160 alumnas y alumnos.
nombres entre los ganadores fue un momento que jamás olvidaré”, dijo.
También se entregaron reconocimientos a docentes destacados que participan en la coordinación de las academias de los 56 planteles del Cecyteg, a fin de mejorar la calidad en los procesos e indicadores educativos.
Angélica Medina, Directora del Cecyteg, compartió un emotivo mensaje: “Ustedes son un ejército de hombres y mujeres que apuestan para que la vida de los estudiantes cambie y el día de mañana den personas de bien”.
Ustedes representan una parte de ese esfuerzo que alberga cada uno de sus recintos, cada uno de los lugares donde se preparan para sacar a flote ese talento, ingenio y creatividad que vive en muchos de los estudiantes que se encuentran en sus escuelas”
Melanie Murillo Presidenta Municipal de Silao

La Gobernadora encabezó la reunión anual donde se entregaron premios por años de servicio
REDACCIÓN
Como cada año, el ISSEG realizó este evento, en el que el Gobierno del Estado propicia una sana convivencia y contacto entre los jubilados y pensionados, quienes han entregado su fuerza y juventud al progreso de Guanajuato y al bienestar de sus familias, con su trabajo, esfuerzo y dedicación de muchos años.
“Nuestras jubiladas y nuestros pensionados son el corazón de Guanajuato. En este Gobierno de la Gente hacemos un reconocimiento a su trabajo, a su dedicación por la Entidad. Sepan que tienen en mí a una aliada, a una Gobernadora que va a trabajar para que este insti-
LIBIA GARCÍA INAUGURÓ EL FORO
NACIONAL MINERO EN EL MARCO DE LA 11° REUNIÓN ANUAL DE COOPERACIÓN Y CORRESPONSABILIDAD PARA LA PRODUCTIVIDAD LABORAL Y EMPRESARIAL, DEL SINDICATO NACIONAL DE TRABAJADORES MINEROS, METALÚRGICOS, SIDERÚRGICOS Y SIMILARES DE LA REPÚBLICA MEXICANA (SNTMMSSRM)
“HOY QUIERO RECONOCER A LAS MUJERES AL FRENTE DE LA MINERÍA, QUE TAMBIÉN HAN TRANSFORMADO ESTA INDUSTRIA Y QUE HOY SIGUEN SIENDO UN EJEMPLO; SIGAN ADELANTE, SIGAN TRABAJANDO POR DEMOSTRAR QUE TAMBIÉN LAS MUJERES DE MÉXICO HEMOS CONSTRUIDO ESTA PATRIA GRANDE QUE NOS LLENA DE ORGULLO”, MANIFESTÓ LA MANDATARIA.
orgullo y el mejor del País”, expresó Libia Dennise García Muñoz Ledo. Se realizó una rifa de regalos para los asistentes previo al evento protocolario; posteriormente se entregaron reconocimientos por años de servicio y el evento culminó con baile y ambientación musical a cargo del cantante José María Napoleón.
En esta ceremonia también estuvieron presentes la Alcaldesa de León, Alejandra Gutiérrez; el Secretario de Finanzas, Héctor Salgado Banda; la Secretaria del Nuevo Comienzo, Rosario Corona Amador; la Directora General del ISSEG, Judith Juárez Guzmán; y la Rectora General de la UG, Claudia Susana Gómez López.


La Alcaldesa de Guanajuato aseguró que el recurso era en beneficio de familias
REDACCIÓN
Samantha Smith recordó que este recurso federal ayudaba a miles de familias en municipios donde la minería es una de las principales actividades económicas.
“Representaba una esperanza tangible para miles de familias en los municipios donde la minería es y ha sido su principal actividad económica. Se destinó en su momento a proyectos de infraestructura, educación y servicios básicos como la salud y hemos sentido su ausencia”, afirmó la Alcaldesa. Smith resaltó la riqueza cultural, arquitectónica y tradicional que esta actividad ha aportado a Guanajuato, una ciudad que nació gracias a la explotación de la plata y hoy, además, es uno de los mejores destinos turísticos del País. Napoleón Gómez Urrutia, Presidente y Secretario General del Sindicato Nacional de Mineros, destacó la participación de más mujeres en labores operativas en esta industria, contribuyendo a que sea una de las principales actividades económicas de México.
Las ventas en Estados Unidos de la industria guanajuatense podrían incrementar si el sector aprovecha artículos waterproof y tradicionales
MICHELLE GUTIÉRREZ
Aunque el principal producto estatal que se exporta a Estados Unidos es la bota vaquera, el Presidente de la Cámara de la Industria del Calzado del Estado de Guanajuato (CICEG), Mauricio Battaglia Velázquez, expresó que la industria tiene que apuntar a la producción de zapato waterproof (a prueba de agua) y artesanal, cuyo precio en el mercado del gigante vecino norteamericano asciende hasta los 10 mil pesos por par.
“Hay un tipo de manufactura de calzado llamado Goodyear Welt, en el que, quienes cosen, pueden llegar a tener sueldos de 30 mil hasta 50 mil pesos mensuales. Entonces, es un círculo positivo y tenemos que ir para allá con productos que sean mejor pagados, que sean rentables para las empresas y los empleados de las fábricas”, explicó Battaglia Velázquez.
A grandes rasgos, Goodyear Welt es un proceso de elaboración de calzado artesanal y tradicional que permite reemplazar la suela en caso de que se descomponga. Este método de colocación es uno de los más reconocidos

Labores. El Municipio realiza monitoreos constantes en cantinas y similares.
2,700 millones de pares de zapatos consume anualmente el mercado estadounidense
37 millones de pares provienen del mercado mexicano


La Alcaldesa de Silao otorgó todo su apoyo a los operativos que realizará GTO en Seguridad
La Alcaldesa de Silao, Melanie Murillo, respaldó el despliegue operativo de revisión en bares, cantinas, restaurantes y anexos de Guanajuato al ser posibles “focos rojos” de seguridad para el Estado. La Mandataria señaló estar dispuesta a colaborar con lo establecido por la Gobernadora Libia Dennise García, para dar paz a los silaoenses.
“La disposición dada por la Gobernadora y la Secretaría de Seguridad será siempre bienvenida. Beneficia a todos
Salarios. En Estados Unidos, los sueldos pueden oscilar entre los 30 mil y 50 mil pesos mexicanos por la rentabilidad de la cual se benefician las empresas.
a nivel internacional, que se caracteriza primordialmente por proporcionar una mayor estabilidad, impermeabilidad y duración.
Asimismo, es una de las metodologías de fabricación de zapato de alta calidad más antiguas del mundo, con su origen en 1869, y con el que se elaboran desde botas vaqueras y de trabajo, hasta zapatos bostonianos.
“Hay un mundo de grandes posibilidades de crecimiento en Estados Unidos. Hay zapatos manufacturados en la República Mexicana que llegan a venderse en hasta 10 mil pesos”, concluyó el Presidente de la CICEG.
los guanajuatenses. Estaremos en colaboración como lo hemos dispuesto desde el inicio, con la Federación, Estado, Municipio”, comentó Murillo. Este operativo fue anunciado para prevenir hechos delictivos como el multihomicidio ocurrido el pasado 30 de noviembre en Apaseo el Grande. Asimismo, Murillo sostuvo que en Silao realizan de forma constante operativos de vigilancia en dichos sitios, y reiteró que mantendrá la colaboración con autoridades estatales para contribuir con lo dictado desde el Estado.
A LA EJECUCIÓN DE LA NUEVA ESTRATEGIA DE SEGURIDAD, GUANAJUATO HA LOGRADO DISMINUIR LOS HOMICIDIOS DOLOSOS Y ROBOS AL TRANSPORTE FEDERAL
REDACCIÓN
A dos meses de su implementación, la estrategia de Coordinación Operativa de la Nueva Fuerza de Inteligencia Anticrimen (CONFIA) registra avances construir un Estado más seguro.
La iniciativa disminuyó en noviembre un 16.94% los homicidios dolosos y redujo 54.79% el robos a transporte federal, gracias a la coordinación entre las Fuerzas de Seguridad Pública del Estado (FSPE), la Secretaría de la Defensa Nacional (Sedena), Guardia Nacional y policías municipales.
Si bien en octubre hubo 307 homicidios dolosos, en el último mes bajaron a 255. Además, los robos al transporte federal en carreteras de GTO pasaron de 188 a 85 en el mismo lapso.
En ese periodo, la Subsecretaría de Inteligencia Operacional participó en la integración de 26 carpetas de investigación relacionadas con delitos como robo de autotransporte federal, de hidrocarburo y delincuencia organizada.

La seguridad también se reforzó vía aérea. En estos dos meses, las aeronaves Arcángeles y Tornados efectuaron 96 vuelos de patrullaje como parte de labores de reconocimiento y reacción.
Por su parte, el Escuadrón Antiextorsión participó en 10 casos de este crimen y secuestro virtual, implementando acciones operativas para salvaguardar la integridad de las víctimas.
A estas acciones se suman operativos de las FSPE en los 46 municipios del Estado. Las acciones abarcaron blindaje en León, Silao, Celaya, Salamanca, San Francisco del Rincón, Jerécuaro, Acámbaro y San Miguel de Allende, además de vigilancia en corredores industriales y tramos carreteros.
Por último, trabajar con instituciones educativas es tan relevante como las labores de inteligencia delictivas.
Así, el Centro Estatal de Prevención Social de la Violencia y Delincuencia realizó dos mil 366 acciones, impactando a 189 mil 802 guanajuatenses, gracias a ponencias, talleres y más.
9 armas largas
10 armas cortas
214 cartuchos
10,194 mil dosis de cristal

970 de cocaína

45 vehículos
1,244 de piedra base
87 motocicletas
14 cajas secas
15 tractocamiones
4,
262 de marihuana

417 personas detenidas

RESULTADO TOTAL
17,481 aseguramientos CONFIA
EPISODIO 05:30 PM

TV4 Noticias de la tarde
02:30 pm
Ciudad Kaboom 03:30 pm

MAÑANA:
TV4 Noticias de la mañana
05:49 am
Cada Día Norteamérica
08:00 am
Mesa para trece 11:00 am
TARDE:

Detrás de un click
12:00 pm
Birli Birloque 12:30 pm
Soñadores
01:00 pm
La Chunchetería 01:30 pm

De rebote 04:30 pm
La banda de Andy 05:00 pm
Pequeños ingenios 05:30 pm

NUEVO EPISODIO
La ruta de hoy 06:00 pm
El Depa 4 06:30 pm
NOCHE:

FascinArte 07:30 pm

TV4 Noticias Norteamérica 08:30 pm

Piano en el Ático 09:30 pm FIC 2024
Vocalconsort Berlin 10:30 pm
MADRUGADA:
TV4 Noticias Norteamérica (Repetición) 12:00 am
Piano en el ático 01:00 am
Documentales: Transilvania, entre la tradición y la modernidad 02:00 am
Piano en el ático 03:00 am

Mundo tortuga 04:00 am
FascinArte 04:00 am
Rodando caminos 05:30 am

MAÑANA:
Informativo DW 06:00 am
TV4 Noticias de la mañana
07:00 am
Informativo TV4 Noticias 08:00 am Reacción con Memo Villegas
09:00 am
Agenda Internacional 10:00 am

México ahora con David Mojaraz
10:00 am
Hora 11, las noticias a fondo con Carlos Lara 11:00 am
HORARIO 09:00 AM
TARDE:
Periscopio Informativo 12:00 pm
De haber sabido con Lupita Atilano 01:00 pm

Hablemos de discapacidad 02:00 pm
Desde el Forum 02:30 pm
Por amor al arte 03:30
Impuso sonoro 04:30 pm
Agenda Internacional con Juan Gabo González 05:00 pm

Series China
Dentro de las Bellas Artes de China 05:30 pm
Periscopio 06:00 pm
NOCHE: León Light Fest 07:00 pm
Noticias en la RED 07:30 pm
Enlace migrante 08:00 pm

Por amor al arte 08:30 pm
TV4 Noticias Norteamérica 09:30 pm
La Azotea 10:30 pm
Alma Caribe 11:00 pm
MADRUGADA:
Por amor al arte 12:00 am
TV4 Noticias Norteamérica
01:00 am
Hora 11, las noticias a fondo con Carlos Lara 02:00 am
La Azotea 03:00 am
De haber sabido 04:00 am
Enlace migrante 05:00 am

am



NUEVO ESPISODIO 09:00 PM CANAL 4.4

MAÑANA: Talento deportivo 06:30 am
Un gol al arcoiris
07:00 am
Actívate TV4

Todo deporte 08:00 am
Revoluciones por minuto 08:30 am
Instinto natural 09:00 am
Nada nos para 09:30 am
Una cancha llamada Medellín 10:00 am
La ciencia del deporte: Psicología 10:30 am

Zona activa 11:00 am Liga Premier Lobos vs. Aguacateros (Repetición) 11:30 am
TARDE:

Futbol entre líneas 01:30 pm
Talento deportivo 02:30 pm
Un gol al arcoíris 03:00 pm
Todo deporte 03:30 pm
TV4 Deportes Informativo 04:00 pm
Revoluciones por minuto 05:30 pm
Entrevista especial: Andrés Guardado 06:00 pm
NOCHE: TV4 Deportes Informativo 07:00 pm
Que lo digan ell4s 08:00 pm
Los colores del futbol 08:30 pm
Revoluciones por minuto 09:00 pm
La ciencia del deporte: Psicología 09:30 pm
Futbol entre líneas 10:00 pm
Sombras en los juegos 11:30 pm
MADRUGADA:
Una cancha llamada Medellín 12:00 am
La ciencia del deporte: Gravedad 12:30 am
Talento deportivo 01:00 am
Que lo digan ell4as 01:30 am

Mi ciudad en bicicleta 02:00 am
Futbol entre líneas 02:30 am
Todo deporte 03:30 am
Revoluciones por minuto 04:00 am
En forma 04:30 am
Salud y deporte 05:30 am

MAÑANA:
La Casa de Lula Sí
06:00 am
La Chunchetería
07:00 am
Pie Rojo
08:00 am
Los cuentos de Chaski
08:30 am
De haber sabido 09:00 am
Hablemos de discapacidad 10:00 am

Turismo extremo 10:30 am
Por amor al arte 11:00 am

HORA: TV4 NOTICIAS 07:00 am INFORME 94/7 02:00 pm QUE RUEDE EL BALÓN 05:00 pm METRÓPOLIS 94.7 06:00 pm EL CLUB 06:00 pm PARADISCO 09:00 pm
TARDE:
Hora 11, noticias a fondo con Carlos Lara 12:00 pm
Encuentro de negocios
01:00 pm
Encuentro animal: Una madre para dos canguros arborícolas 01:30 pm
Planeta humano 02:00 pm

Animales maravillosos: Delfines 03:00 pm
Turismo extremo 03:30 pm
TV4 Noticias de la tarde 04:00 pm
Birli Birloque 05:00 pm
Soñadores 05:30 pm
La Chunchetería 06:00 pm
NOCHE: Ciudad Kaboom 07:00 pm

El Depa 4 08:00 pm
El sol a mi lado 09:00 pm
Documentales: La maldición de ganar la lotería 10:00 pm
TV4 Noticias Norteamérica 11:00 pm
MADRUGADA:
Hora 11, noticias a fondo con Carlos Lara 12:00 am
De haber sabido 01:00 am
El Depa 4 02:00 am

Encuentro de negocios 03:00 am
Encuentro animal 03:30 am Por amor al arte 04:00 am Hablemos de discapacidad 05:00 am

humano 05:30 am


GOBIERNO FEDERAL ANTICIPÓ QUE EN CASO DE QUE OCURRAN LAS DEPORTACIONES MASIVAS, PEDIRÁN A DONALD TRUMP QUE NO MANDEN A TODOS A MÉXICO
AGENCIA REFORMA
La Presidenta Claudia Sheinbaum afirmó que solicitará a Donald Trump que, en caso de deportaciones, envíe a los migrantes directamente a sus países de origen. En conferencia en Palacio Nacional, la Mandataria explicó que al momento existe un acuerdo con el Presidente Joe Biden, mediante el cual Estados Unidos se hace cargo
de mandar a los inmigrantes de algunas nacionalidades de regreso a sus países de origen sin que regresen necesariamente a México.
“Evidentemente, nosotros somos solidarios con todos y con todas, pero nuestra principal función es recibir a las y los mexicanos. Esperamos tener un acuerdo con la Administración Trump en caso de que haya estas deportaciones”, comentó.
+11
MILLONES de inmigrantes se encuentran en situación irregular en Estados Unidos
+5
MILLONES son de origen mexicano
Fuente: Migration Policy Institute
El Gobierno de Trump barajea opciones de países para que acepten inmigrantes CUANDO SUS PAÍSES DE ORIGEN SE NIEGUEN A ACEPTARLOS; al momento han rechazado la propuesta:
l Bahamas l Islas Turcas y Caicos l Panamá
del norte del País a una reunión para abordar el plan a seguir en caso de una deportación masiva, una vez que Donald Trump asuma la Presidencia de Estados Unidos en enero próximo.
“La Secretaría de Gobernación va a convocar a la Gobernadora de Baja California, de Sonora, de Chihuahua, de Coahuila, Nuevo León y Tamaulipas para poder tener esta reunión en donde nos pongamos de acuerdo cómo recibir a nuestros paisanos y paisanas en caso de que haya una deportación masiva”, dijo.
Hay más de 11 millones de inmigrantes en situación irregular en Estados Unidos y más de cinco millones son de origen mexicano, de acuerdo con el Migration Policy Institute.
La amenaza de Trump de deportar hasta un millón de personas cada año ha puesto en alerta a las autoridades mexicanas y ha desbordado las dudas sobre la capacidad del País de absorber esa carga y evitar que la frontera se convierta en un cuello de botella.
Algunos especialistas de la relación bilateral han puesto en duda la capacidad del plan estadounidense, aunque el nuevo equilibrio político, donde los republicanos controlan ambas Cámaras del Congreso y la distribución de los recursos públicos, puede traducirse en la expulsión de cientos de miles cada año.

VA CANCILLER A CENTRO DE DETENCIÓN
COMO PARTE DE LA PREPARACIÓN ANTE LA DEPORTACIÓN, EL SECRETARIO DE RELACIONES EXTERIORES, JUAN RAMÓN DE LA FUENTE, VISITÓ EL CENTRO DE PROCESAMIENTO DE LA OFICINA DEL SERVICIO DE CONTROL DE INMIGRACIÓN Y ADUANAS EN DALLAS, TEXAS. EL OBJETIVO DEL VIAJE FUE COORDINAR LA RESPUESTA DE LOS 53 CONSULADOS MEXICANOS EN TERRITORIO VECINO, LA RED CONSULAR MÁS GRANDE EN EL MUNDO, Y AVANZAR EN EL PLAN PARA RECIBIR A DECENAS DE MILES DE INMIGRANTES.
1

APREHENSIÓN
DETIENEN A ‘COCINERO’ DE FENTANILO
➜ En un operativo federal en Sinaloa, se capturó a Adrián “N”, “El Gallero”, químico encargado de la elaboración de fentanilo para un grupo delictivo de los Beltrán Leyva. En su arresto, en el Municipio de Ahome, se decomisaron más de mil kilos del opioide.

2
MOVIMIENTO CIUDADANO
ASUME COMO DIRIGENTE NACIONAL
➜ En la 5° Convención Nacional Democrática de Movimiento Ciudadano, Jorge Máynez fue nombrado dirigente nacional del partido naranja: “El proyecto ha tomado decisiones correctas, necesitamos una nueva estrategia y mirar al futuro con optimismo”.
3

PRI
RENUNCIA TRAS MÁS DE CUATRO DÉCADAS
➜ Enrique de la Madrid, exaspirante presidencial interno de la coalición opositora en 2024, renunció a su militancia en el PRI, partido en el que estuvo desde 1980, y en el que consideró que su “ciclo ha terminado”, por lo que buscará “otros espacios”.

4
EMPRESARIOS
PRESENTA SHEINBAUM EL PLAN MÉXICO
➜ La Presidenta Claudia Sheinbaum Pardo sostuvo una reunión con 54 integrantes del Consejo Mexicano de Negocios (CMN), a quienes les presentó el Plan México, con el cual buscará incrementar la inversión en el País, y aumentar la producción nacional.
Más de una docena de menores de edad habrían perdido la vida en el Estado de México por el bacilo Klebsiella Oxytoca
SÍNTOMAS
POR KLEBSIELLA OXYTOCA l Fiebre alta y escalofríos l Taquicardia l Dificultad para respirar l Confusión mental en etapas avanzadas l Signos de sepsis, como caída de la presión arterial
REDACCIÓN
Tras recibir el 29 de noviembre la notificación de autoridades del Estado de México ante la identificación de un posible vínculo entre casos, la Secretaría de Salud (Ssa) federal reportó el fallecimiento de 13 menores de edad, de 0 a 14 años, por un brote de infección del torrente sanguíneo (ITS) causado por la bacteria Klebsiella Oxytoca en tres hospitales públicos y una clínica privada en dicha Entidad.
La dependencia federal estudió un total de 20 casos, de los cuales cuatro continúan como probables y sólo uno ha sido descartado.
El brote de infecciones se habría originado por una posible contaminación de soluciones intravenosas de nutrición parenteral total (NPT) distribuidas por la empresa Productos Hospitalarios S.A. de C.V., con sede en Toluca, Estado de México.
De acuerdo con los informes, estas mezclas habrían sido utilizadas desde el 21 de noviembre.
l Recién nacidos, en especial aquellos en cuidados intensivos l Adultos mayores con sistemas inmunitarios débiles l Pacientes con cáncer, VIH o enfermedades crónicas graves l Pacientes que utilicen dispositivos como catéteres o ventiladores
“De los 20 casos, se registraron 13 defunciones de pacientes que poseían comorbilidades, por lo que están en proceso de dictaminación para determinar si la causa de muerte está asociada a la Klebsiella Oxytoca. Asimismo, siete pacientes continúan hospitalizados y reciben atención médica de los servicios de salud del Estado de México”, comunicó la Ssa.
Por el brote, el Sistema Nacional de Salud emitió una Alerta Epidemiológica, y la Comisión Federal para la Protección contra Riesgos Sanitarios (Cofepris) inhabilitó la distribución de mezclas posiblemente infectadas, advirtiendo “sobre la inmovilización de forma preventiva y suspensión de la administración de soluciones intravenosas de nutrición parenteral”.
Lo anterior resulta una medida de prevención en lo que concluyen las investigaciones que llevan a cabo la Ssa, a través de la Dirección General de Epidemiología (DGE), el Instituto de Diagnóstico y Referencia Epidemiológicos (Indre), la Cofepris y la Secretaría de Salud del Estado de México.
Cabe mencionar que, por la mañana del 5 de diciembre, la Presidenta Claudia Sheinbaum Pardo, en su conferencia de prensa matutina aseguró que el brote “ya está controlado”.
Macron dijo que la renuncia de Michel Barnier no pone en riesgo su continuidad





El Presidente francés anunció el jueves que nombrará “en los próximos días” un Primer Ministro para sustituir a Michel Barnier, destituido por el Parlamento, al tiempo que descartó renunciar y acusó a la ultraderecha y la ultraizquierda de haberse unido para sembrar el desorden.
“El mandato que ustedes me confiaron democráticamente es de 5 años y lo ejerceré cabalmente hasta el final, en 2027”, subrayó, en momentos en que se multiplican los llamamientos para que dimita.
La razón del despido de Barnier fue por el rechazo de su presupuesto para 2025, que incluía medidas de austeridad que él consideraba indispensables para estabilizar las finanzas del País.

Tensión. Ocurre previo a reapertura este sábado de Notre Dame.


EL HOMICIDIO DEL MÁXIMO EJECUTIVO DE UNITED HEALTHCARE APUNTARÍA A UNA REPRESALIA POR EL RECHAZO DE LA COMPAÑÍA A CUBRIR TRATAMIENTO
La Policía neoyorquina revisó el jueves las imágenes de las cámaras de seguridad de calles y edificios en una búsqueda desesperada del autor de la muerte del máximo ejecutivo de la mayor compañía de seguros médicos de Estados Unidos.
Se divulgaron imágenes del tirador, vestido con un chamarra oscura con capucha y mascarilla, que disparó por la espalda al Consejero Delegado de Unitedhealthcare, Brian Thompson, frente al Hotel Hilton, una de las zonas más concurridas de Manhattan.
La Comisionada de la Policía de la ciudad, Jessica Tisch, informó que el atacante había esperado a Thompson, de 50 años, ignorando a otros transeúntes, cuando se acercaba a una puerta de entrada del hotel donde tenía previsto intervenir en la conferencia anual de inversores. Todavía no eran las 7:00 hrs. “Todos los indicios apuntan a que se trata de un ataque premeditado, planeado con antelación y dirigido contra un objetivo concreto”, declaró. El asesino huyó en bicicleta en dirección a Central Park, hasta que se perdió por completo su rastro.
RELEVANCIA DE EMPRESA
1°
empresa de atención médica más grande del mundo por ingresos
8°
lugar en la lista Fortune Global 500 de 2024
$474.3 MIL
millones de dólares es su capitalización en el mercado internacional
En los casquillos de bala hallados en el lugar del tiroteo se encontraron, según la Policía, mensajes como “retrasar”, “denegar” y “destituir”
Las tres palabras hacen referencia a una frase popular que es comúnmente utilizada por abogados y críticos de la industria de seguros: “Retrasar, negar, defender”.
Aunque se desconocen las motivaciones, la esposa del ejecutivo Paulette Thompson declaró a NBC News que su marido había recibido amenazas Padre de dos hijos, Thompson llevaba más de 20 años en la compañía y desde 2021 dirigía su filial de salud UnitedHealthcare.
Su división ha sido objeto de críticas, tanto de reguladores federales como de particulares. que la acusan de denegar pruebas médicas y tratamientos a los asegurados.


GRUPO A GRUPO E



GRUPO B


GRUPO C




DEL 15 DE JUNIO AL 13 DE JULIO DE 2025, EL MUNDO VIBRARÁ CON EL RENOVADO TORNEO DE CLUBES; FLAMENGO, CHELSEA Y ES TUNIS: LOS RIVALES DE LEÓN
REDACCIÓN
Las emociones del Mundial de Clubes 2025 dieron su banderazo de salida con la asignación de los 32 participantes en sus respectivos grupos, donde todos tendrán como única misión alzarse como los reyes del futbol.
La Fiera fue el primer equipo sorteado. En medio de la polémica sobre la multipropiedad y si podrá jugar o no el certamen, disputará la fase de grupos en el sector D, donde competirá ante el Flamengo de Brasil, el ES Tunis de Túnez y el Chelsea de Inglaterra.
Sudamericano en 2022, ganó la Serie
A brasileña en 2019 y 2020, así como la Copa de Brasil en 2022 y 2024.
Esperance Sportive perdió la última Champions League de la Confederación de África ante el Al Ahly de Egipto.
Su pase al Mundial lo lograron gracias a su buen ranking debido a sus destacadas participaciones en los torneos internacionales en su continente.
El Presidente del Club León, Jesús Martínez Murguía, confirmó que se harán refuerzos de renombre que permitan al equipo sea mucho más competitivo en el certamen.


GRUPO F



GRUPO G
CONFIRMAN VENTA
Jesús Martínez Patiño, propietario de Grupo Pachuca al que pertenecen



El choque ante los Blues será el primero en la historia de ambas instituciones. El cuadro de Londres ha ganado cinco veces la Premier League desde 2005, dos Champions League, así como un Mundial de Clubes, cinco FA Cup y tres Copas de la Liga.


GRUPO D GRUPO H
Un viejo conocido para los Esmeraldas será el Flamengo, conjunto brasileño que enfrentó y venció en la fase de grupos de la Copa Libertadores 2014. Aunque, pasado el tiempo, se consagró monarca del máximo torneo
León y Pachuca, anunció que La Fiera será puesta a la venta para que la FIFA respete el derecho de ambos clubes a competir en 2025, al estar prohibida la multipropiedad en el reglamento.
Patiño confió que con la medida se les respetará lo que ganaron en la cancha. En próximas semanas se dará a conocer la resolución definitiva.



AMÉRICA Y CRUZ AZUL EMPATARON
0-0 EN LA SEMIFINAL DE IDA EN BUSCA DE UN BOLETO AL JUEGO POR EL TÍTULO
AGENCIA REFORMA
Nada para nadie en el Estadio Ciudad de los Deportes. Los primeros 90 minutos de la serie Cruz Azul contra América vivieron un duelo más digno de pretemporada que de Liguilla, provocado por la postura conservadora de ambas plantillas.
Bajo un gran ambiente en las tribunas, ambos equipos dejaron a los aficionados sin grito de gol con un empate 0-0 en la ida de las semifinales del Apertura 2024. Pese a ser un juego en el medio campo, ninguno de los dos equipos logró mover el marcador
En un primer tiempo de escasas emociones, Cruz Azul tuvo la mejor oportunidad al 7’, cuando Carlos Rotondi ensayó el disparo de zurda desde fuera del área y exigió el lance y la atajada del portero americanista Ángel Malagón.
Al 59’, el guardameta colombiano Kevin Mier evitó la caída del arco celeste dos veces consecutivas, primero al tapar un remate en corto del uruguayo Brian Rodríguez y después al desviar por encima del larguero un tiro de media distancia de Alan Cervantes.


AMÉRICA VS. CRUZ AZUL

JUEGOS DE VUELTA MONTERREY VS.
1-2
20:00 hrs
Sábado 7 de diciembre
Canal 5 - Azteca 7


CRUZ AZUL VS. AMÉRICA
0-0
19:00 hrs
Domingo 8 de diciembre TV: Canal 5 - Azteca 7
AGENCIA REFORMA
Sergio Pérez se mantiene firme con su postura y apela a su contrato para asegurar que continuará con Red Bull para la temporada 2025.

El argentino Gonzalo Piovi cobró un tiro de esquina al 64’, el balón iba para gol olímpico del equipo cruzazulino, pero Malagón lo despejó por lo alto con ambas manos.
A pesar que nadie salió con la victoria, La Máquina del argentino Martín Anselmi llegará al juego de vuelto con una ligera ventaja, ya que con una victoria por cualquier marcador, o hasta con el empate, pasarán a la gran final gracias al criterio de desempate de posición en la tabla (Cruz Azul, 1°; América, 8°).
El partido de vuelta de esta eliminatoria se jugará este domingo, también en el Estadio de la Ciudad de los Deportes, donde el América debe ganar para pasar a la final
La primera semifinal se puso en marcha el miércoles en el Estadio Alfonso Lastras donde el Atlético San Luis venció 2-1 al Monterrey. Esta llave se cerrará el sábado. Monterrey deberá ganar el partido por cualquier marcador para avanzar a la final.
y conduciré para Red Bull el año que viene. Ya lo he dicho. No hay nada más que añadir”, dijo en el circuito Yas Marina. El mexicano restó importancia a los rumores sobre su continuidad y prefirió enfocarse en su rendimiento para la última carrera del año en la Fórmula 1.

A pesar de que en días recientes los rumores afirmaron que Abu Dhabi sería su última carrera en la escudería, Checo insistió en negar su salida del equipo.
ÚLTIMA CARRERA GP DE ABU DHABI
Domingo 8 de diciembre
07:00 hrs TV: Fox Sports
“Nada ha cambiado en cuanto a lo que he dicho durante todo el año. Tengo un contrato para el año que viene
Con el campeonato de pilotos ya definido en favor de Max Verstappen, todos los ojos se posarán en lo que suceda en el certamen de constructores, que promete una definición emocionante entre McLaren y Ferrari. La escudería de Woking llega a Abu Dhabi como líder, con 640, en busca de lograr su primer campeonato de equipos desde 1998; pero los de Maranello, que suman 619 unidades, intentarán impedirlo y llevarse la corona a Italia.


NFL
RUGEN LEONES A POSTEMPORADA CON DRAMA HASTA LOS ÚLTIMOS SEGUNDOS, LOS DETROIT LIONS VENCIERON 34-31 A GREEN BAY PACKERS EN EL ARRANQUE DE LA SEMANA 14 DE LA TEMPORADA. EL EQUIPO DE MICHIGAN IMPUSO UNA RACHA HISTÓRICA DE 11 VICTORIAS CONSECUTIVAS, DEJÓ SU MARCA EN 12-1 Y AMARRARON SU PASE A LOS PLAYOFFS A FALTA DE CUATRO ENFRENTAMIENTOS.

l JUAN CARLOS COLUNGA, con más de 15 años de experiencia en el mundo de la producción audiovisual l EMMANUEL DELGADO, realizador audiovisual con 10 años en el ámbito l OMAR ALCALÁ, cineasta leonés
El PRIMER LUGAR
OBTENDRÁ 40 MIL PESOS, el segundo 20 mil y el tercero 10 mil pesos

Participantes. El jueves se proyectaron 13 videos y este viernes los 13 restantes.
MÁS DE 220 UNIVERSITARIOS DE VARIAS ENTIDADES PARTICIPAN EN LA 7° EDICIÓN DE LEÓN LIGHT FEST
REDACCIÓN
Los estudiantes fueron los encargados de iluminar y mostrar videos interactivos en la fachada del Teatro Bicentenario Roberto Plascencia Saldaña.
La Alcaldesa, Alejandra Gutiérrez, destacó que en el Municipio hay mucho talento y espacios donde los jóvenes pueden mostrar sus ideas, su creatividad y su aprendizaje.
“Lo más padre es siempre buscar incluir a los jóvenes y a nuevos talentos, este es el ejemplo porque vemos cómo apoyar a los talentos para que puedan presentar ese trabajo extraordinario de poder mapear cualquier espacio público, lo hemos visto en el Centro, en el Expiatorio, aquí, vemos el trabajo maravilloso que implica capacitar,
preparar, que los jóvenes sueñen y aprendan y confíen en ellos, que no tienen límites y pueden lograr cualquier cosa”, dijo la Presidenta Municipal.
La temática central de esta edición fue “El Espacio” con la participación de 44 equipos de diferentes Estados de la República; de ellos, 26 lograron clasificar a la final.
Bernardo Larraguivel, Director de León Light Fest, comentó que el objetivo del evento es desarrollar el talento de los estudiantes universitarios, así como combinar la tecnología con la innovación y las artes visuales.
“Estoy convencido que en la medida que sigamos apostando a estos proyectos, Guanajuato se va a convertir en un semillero de desarrolladores visuales”, dijo Larraguivel.

LIGUILLA Lo dejan para la vuelta
América y Cruz
Azul empatan sin goles; las Águilas están obligadas a ganar el domingo >12
EL CLUB LEÓN ENFRENTARÁ AL FLAMENGO, CHELSEA Y ES TUNIS EN EL MUNDIAL DE CLUBES, QUE SE CELEBRARÁ DEL 15 DE JUNIO AL 13 DE JULIO DE 2025 >11



AMÉRICA VS. CRUZ AZUL
ESTADO DE MÉXICO
Fallecen 13 por brote infeccioso en hospitales
Soluciones intravenosas podrían haber estado contaminadas y ser las causantes >9

CHECO ‘VOY A CORRER AQUÍ EN 2025’
El piloto mexicano pone fin a los rumores sobre su salida de Red Bull
